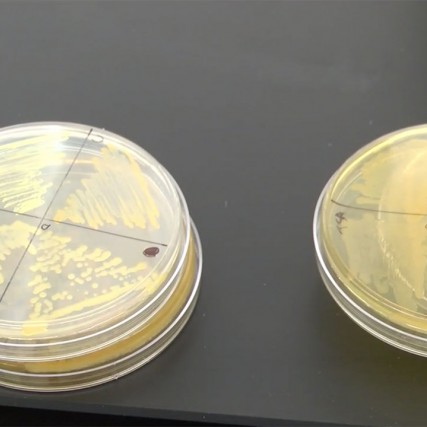
Petri dishes filled with bacteria samples

News
- RIT/
- Hudson Lab/
- News
-
December 4, 2020

RIT begins development of saliva testing for spring semester
RIT is developing saliva testing protocols for campus as part of its plan to monitor the prevalence of the SARS-CoV2 virus, the causative agent of COVID-19. Development of the testing process will be done by André Hudson and Julie Thomas, both faculty-researchers in the Thomas H. Gosnell School of Life Sciences.
-
October 16, 2020

Tiger Alumni Week offers dozens of virtual activities
Virtual reunions, interactive programs, talks, a 5K, e-Sports, and even Tiger Trivia are just some of the dozens of events slated for Tiger Alumni Week, beginning Monday for RIT alumni, students, families, faculty, and staff.
-
October 14, 2020

RIT to host virtual discussion with author, journalist, activist George M. Johnson
RIT’s Inclusive Excellence program will host a virtual discussion with acclaimed author, journalist, and activist George M. Johnson, whose work explores the intersectionality of topics including race, sex, gender, and culture, on Wednesday, Oct. 21.
-
September 14, 2020

Connections: Should the NFL have fans in the stands this season?
WXXI’s “Connections” program features Andre Hudson, professor and head of the Thomas H. Gosnell School of Life Sciences, and a Buffalo Bills fan.
-
September 4, 2020

André Hudson: Encouraging Tomorrow’s Scientists, One Person and One Paper at a Time
Dr. André Hudson is well-known for training students in how to effectively communicate their scientific work, so his new role comes as no surprise. Beginning in January 2021, Dr. Hudson will join academics from universities like Harvard, MIT, and Yale on the Journal of Biological Chemistry (JBC) Editorial Board.
-
July 14, 2020

RIT strategically upgrades campus to prevent the spread of coronavirus
In a biology lab in Gosnell Hall, Professor André Hudson has been spending hours this summer testing products to see whether they are effective at killing and filtering microorganisms such as viruses, bacteria, and fungi. The effort is part of RIT’s Infrastructure and Health Technologies task force, which is putting changes in place to make RIT’s campus as safe and clean as possible in the fall.
-
June 4, 2020

RIT will host ‘Calls for Justice’ vigil on Zoom this Friday
RIT is hosting an online interfaith vigil titled “Calls for Justice at RIT” at 7 p.m. June 5 in response to the killing of George Floyd and the subsequent demonstrations against the systemic racism and police brutality that continue to affect black and brown people across the U.S.
-
May 26, 2020

RIT researchers receive grant to study microplastic pollution in Lake Ontario
A team of RIT researchers will explore how tiny particles of plastic pollution are impacting Lake Ontario thanks to new funding from the National Oceanic and Atmospheric Administration. The multidisciplinary group will examine how microplastics are transported and transformed in the lake, where they ultimately end up and what effects they have on the ecosystem.
-
May 4, 2020

Research propels biotechnology and molecular bioscience student KayLee Steiner to top Ph.D. program
KayLee Steiner knows her way around a research laboratory. Her extensive undergraduate research experience made her an appealing candidate when she began applying to Ph.D. programs. After receiving offers from top-notch graduate programs including Duke, University of North Carolina at Chapel Hill and others, she will pursue her Ph.D. at Vanderbilt University’s School of Medicine.
-
April 10, 2020

Confronting challenges with confidence
Learn about the natural world on a molecular level. Find out how biotechnologists are confronting challenges in the real world.
-
February 20, 2020
Most bacteria found on touch screens is resistant to antibiotics, RIT study finds
WROC-TV talks to Professor André Hudson, head of the Thomas H. Gosnell School of Life Sciences, about antibiotic-resistant bacteria found on touch screens.
-
February 18, 2020

Student to Student: Antibiotic resistance
At the end of her first year at RIT, Nicole Cavanaugh began working for the Hudson Lab. Today, she works as a research apprentice at the Roswell Park Cancer Institute where she is preparing for her Ph.D.